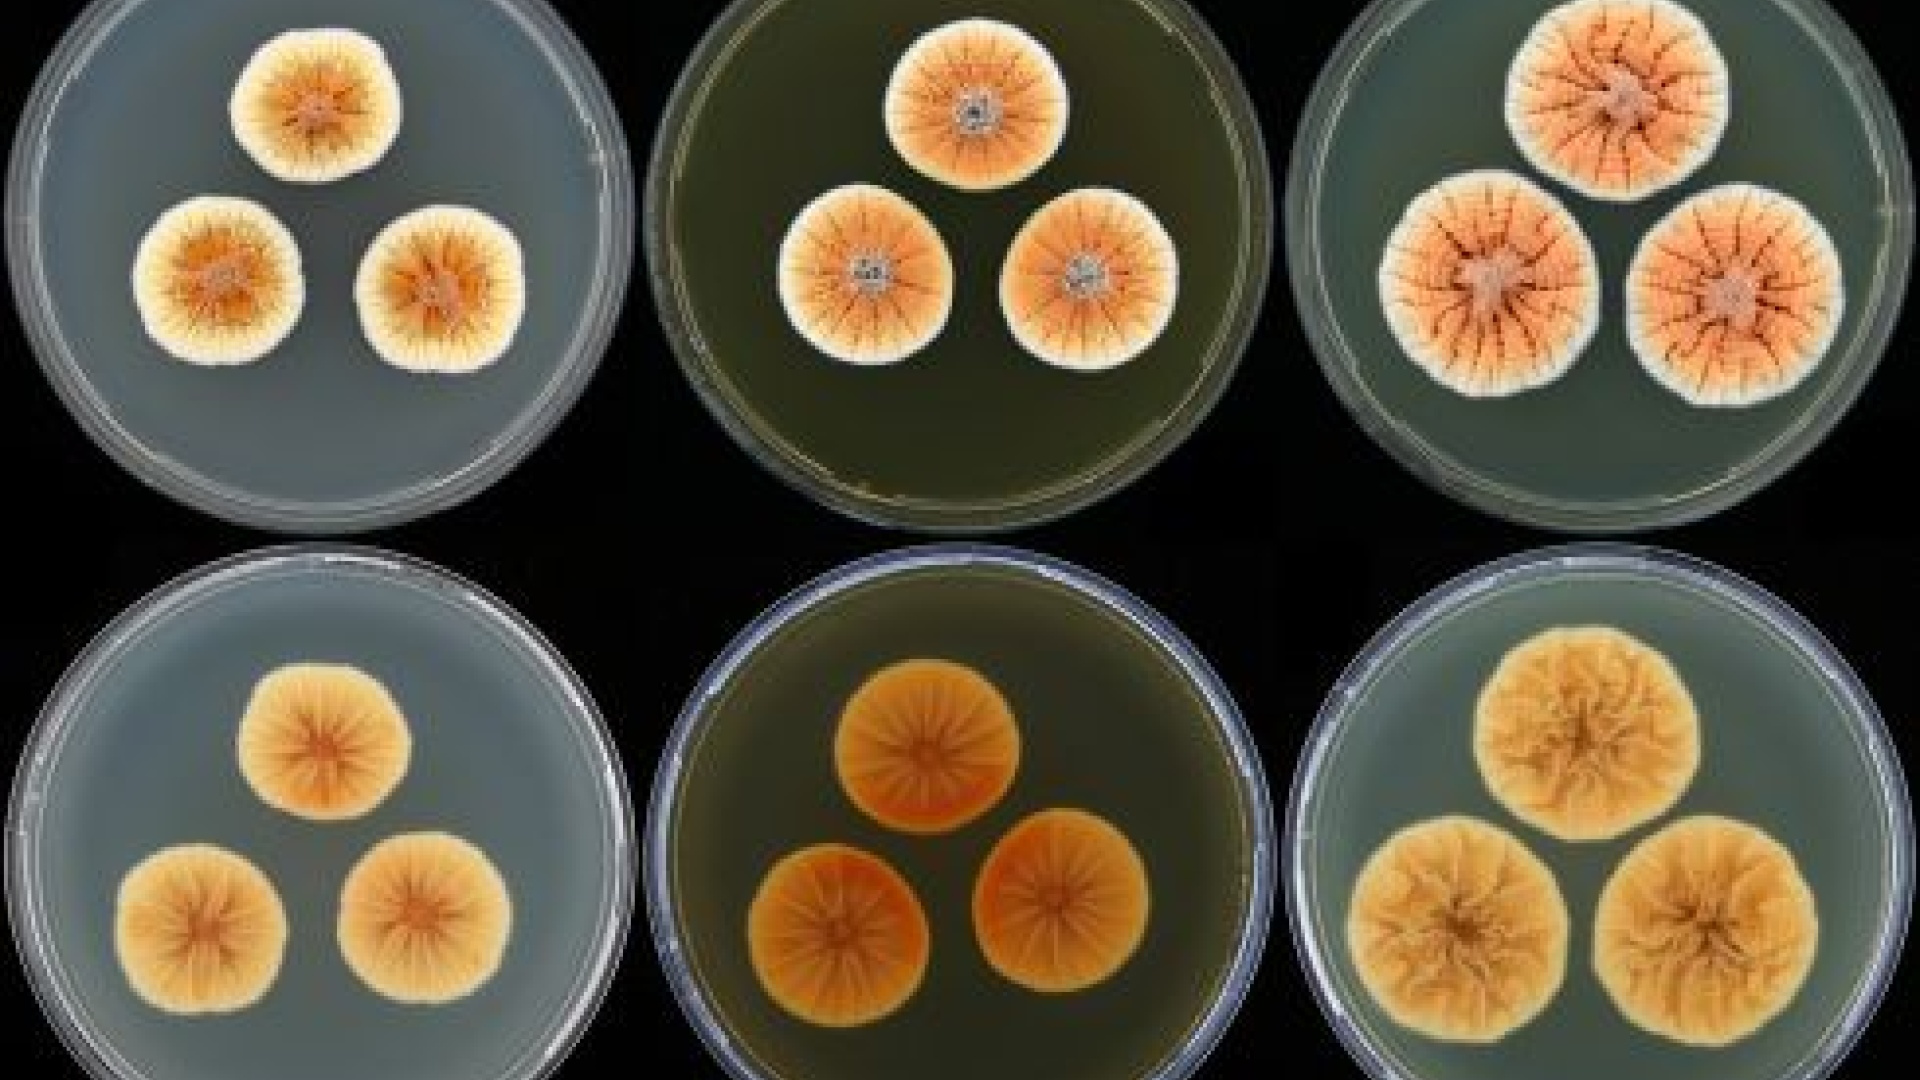
Kuninkaallisia homeita

Alankomaiden tuleva vallanvaihdos on saanut hollantilaistutkijat nimeämään viisi uutta penisilliini-hometta kuninkaallisten mukaan.
Homeisiin erikoistuneen Alankomaiden kuninkaallisen tiedeakatemian alaisen CBS-instituutin tutkijat antoivat Penicillium vanoranje -sukuun kuuluville viidelle alatyypille nimet prinssi Willem-Alexanderin, hänen vaimonsa Máximan ja heidän kolmen tyttärensä mukaan.
Nimistä P. vanoranjei, P. maximae, P. amaliae, P. alexiae ja P. arianeae kerrottiin torstaina Amsterdamissa pidetyssä kokouksessa sekä Personia-julkaisusarjassa ilmestyneessä artikkelissa Five new Penicillium species in section Sclerotiora: a tribute to the Dutch Royal family.
"Kukaan ei ole löytänyt tätä oranssin väristä homeperhettä aikaisemmin, ja koska löytö osuu samaan aikaan kuin maamme kuninkaallisten vallanperimys, kumarramme kunnioittavasti tulevalle kuninkaallemme ja hänen perheellensä nimeämällä nämä penisilliinit heidän mukaansa", kertoo johtaja Pedro Crous CBS-KNAW:n tiedotteessa.
Vaikka homeita tuntuu olevan hyvin eri värisiä, on oranssi kuitenkin hyvin erikoinen väri homeelle. Oranssi on puolestaan Alankomaiden kuninkaallisen suvun van Oranjen tunnusväri. Suku on alun perin kotoisin Ranskan Orange-nimisestä kaupungista, mikä puolestaan on saanut nimensä appelsiineista.
Kyseessä ei ole ensimmäinen kuninkaallinen tiedenimeäminen Hollannissa viime aikoina: vuonna 2005 maastrichtiläiset tutkijat antoivat sydänsairaudesta viestivälle proteiinille nimen kuningatar Beatrixin mukaan.
Kuva: CBS-KNAW